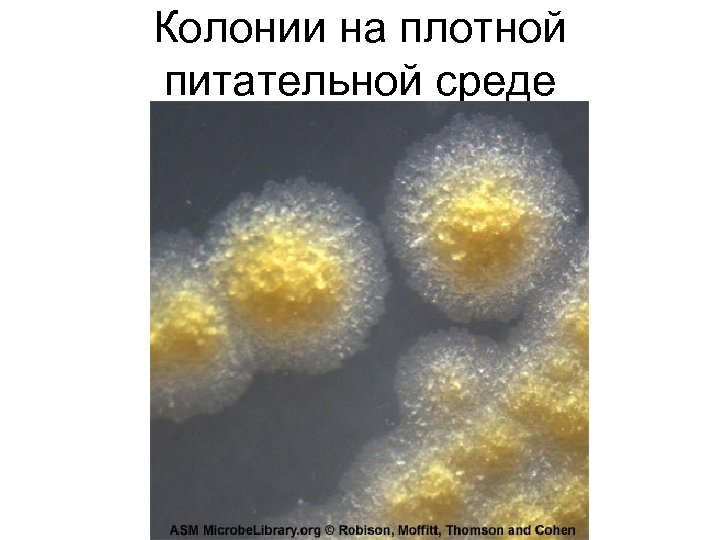
Колонии на плотной питательной среде

68af7b9fc6f1a87ecc11035052a632a0.ppt
- Количество слайдов: 59

ЛЕКЦИЮ ЧИТАЕТ Заведующий кафедрой микробиологии, вирусологии и иммунологии доктор мед. наук, профессор Минухин Валерий Владимирович

К ВНИМАНИЮ СТУДЕНТОВ! • На кафедре микробиологии, вирусологии и иммунологии имеется почтовый электронный адрес – • Present. mikro 1922@ukr. net • Написав на этот адрес запрос Вы можете бесплатно получить презентацию этой лекции. • С ув. проф. В. В. Минухин.

Тема лекции: Микробиологическая диагностика дифтерии и туберкулёза.

ПЛАН ЛЕКЦИИ: • 1. Возбудитель дифтерии. Классификация. Биологические свойства. Методы лабораторной диагностики. Лечение и профилактика. • 2. Возбудитель туберкулёза. Классификация. Биологические свойства. Методы лабораторной диагностики. Лечение и профилактика.

Дифтерия – • острое инфекционное заболевание, которое проявляется глубокой интоксикацией организма, вызванной дифтерийным токсином, и характерным фибринозным воспалением в месте локализации возбудителя.

История вопроса 1883 – 1884 гг – Ф. Леффлер и Э. Клебс выделили и получили чистую культуру возбудителя. 1888 г – Э. Ру и А. Иерсен обнаружили экзотоксин. 1892 г – Э. Беринг получил антитоксическую сыворотку. 1923 г – Г. Рамон предложил иммунизацию дифтерийным анатоксином.

Возбудитель дифтерии Corynebacterium diphtheriae (лат. )

Возбудитель дифтерии — • грамположительные бактерии рода Corynebacterium. • Corynebacterium diphtheriae — крупные, прямые, слегка изогнутые полиморфные палочковидные бактерии. • Длина 1— 6 мкм, • ширина 0, 3— 0, 8 мкм с утолщениями на концах.

• На полюсах клеток локализуются метахроматические зёрна волютина, придавая клеткам характерную форму «булавы» (тельца Бабеша. Эрнста).

• Зёрна волютина окрашиваются метиленовым синим по Нейссеру. • Бактерии в микропрепарате располагаются одиночно, или, вследствие особенностей деления клеток, располагаются в форме латинской буквы V или Y. • Спор и капсул не образуют.


Чистая культура возбудителя

Коринебактерии (окр. синькой)

Культуральные свойства • • • Аэроб и факультативный анаэроб. Температурный оптимум – 37 град. С. Диапазон роста 15 -40 град. С. р. Н среды – 7, 2 -7, 6. Питательны среды – должны содержать белок (сыворотка крови или кровь), сахарный бульон. • Колонии между собой не сливаются.

Колонии C. diphtheriae (сывороточный агар)

По культуральноморфологическим и ферментативным сво йствам различают 3 биовара *gravis; • mitis; • Intermedius. *gravis (сбраживает крахмал), mitis и intermedius (не сбраживают крахмал). Наиболее распространены первые два биовара.

• Возбудителем Д. являются токсигенные коринебактерии дифтерии. • Токсигенные штаммы дифтерийной палочки (лизогенные) обладают геном tox+, • детерминирующим синтез дифтерийного • экзотоксина.

Способность продуцировать экзотоксин не изменяется при: • 1. длительной циркуляции в коллективе иммунных лиц; • 2. лечении больных противодифтерийной сывороткой; • 3. санации бактерионосителей антибиотиками.


Ферментативная активность: • Сбраживают молоко, не разлагают мочевину, не выделяют индол, слабо образуют сероводород, восстанавливают нитраты в нитриты, теллурит калия до свободного теллура (колонии черного цвета).

Факторы патогенности. • 1. Поверхностные структуры липидного и белкового происхождения (кордфактор), К-антигены, миколовые кислоты, ферменты и токсины. • 2. Ферменты агрессии: нейраминидаза, гиалуронидаза, дермонекротоксин. • 3. Экзотоксин.

Возбудитель Д. может длительно сохранять ся на фибринозных пленках, удаленных из очага воспаления (до 3— 5 мес. ), на поверхности сухих предметов и в пыли (до 2 мес. ), в продуктах питания (до 2— 3 нед. ), в трупах (до 2 нед. ). Они быстро погибают под воздействием прямого солнечного света, дезинфицирующих средств, при влажной уборке.


Распространенная дифтерия ротоглотки: серовато-белые отторгающиеся налеты на гиперемированных с цианотичным оттенком небных миндалинах, дужках и язычке.

Дифтерия ( «бычья шея» ) Выраженный отек шеи. Ребенок не может закрыть рот. Язык приподнят. Ринит. Субфебрильная температура. Ребенок погиб от миокардита. Антитоксина не было. Лаос.

Дифтерия кожи

Осложнения дифтерии • связаны с повреждением нервных и других клеток крайне ядовитым дифтерийным токсином. • Миокардиты, нарушения работы нервной системы, которые обычно проявляются в виде параличей. Чаще всего дифтерия осложняется параличами мягкого нёба, голосовых связок, мышц шеи, дыхательных путей и конечностей. • Из-за паралича дыхательных путей может наступить асфиксия (при крупе) и летальный исход.

Иммунитет при дифтерии • После перенесённого заболевания формируется нестойкий иммунитет, и приблизительно через 10 -11 лет человек может заболеть вновь. • Повторное заболевание носит нетяжёлый характер и переносится легче.

Специфическая профилактика • адсорбированная коклюшно-дифтерийностолбнячная вакцина (АКДС-вакцина), • адсорбированный дифтерийно-столбнячный анатоксин (АДС-анатоксин), • адсорбированный дифтерийно-столбнячный анатоксин с уменьшенным содержанием антигенов (АДС-М-анатоксин), • адсорбированный дифтерийный анатоксин с уменьшенным содержанием антигена (АД-М-анатоксин). Вакцинация – в 3 месяца. Ревакцинация – 1, 5 -2 года, 9 -16 лет, далее через каждые 10 лет

Один из первых пузырьков дифтерийного антитоксина (1895), произведённый Гигиенической Лабораторией Соединённых Штатов Америки

• МИКРОБИОЛОГИЧЕСКАЯ ДИАГНОСТИКА ТУБЕРКУЛЁЗА

Туберкулез (от лат. tuberculum - бугорок) • - первично хроническое заболевание человека и животных, сопровождающееся поражением различных органов и систем (органов дыхания, лимфатических узлов, кишечника, костей и суставов, глаз, кожи, почек и мочевыводяших путей, половых органов, ЦНС).

Актуальность темы на сегодня • По данным ВОЗ: • ежегодно 8 миллионов человек заболевают туберкулёзом; • 2 миллиона умирает. • Доминируют лица 18 -26 лет. • В 1995 году ВОЗ объявила эпидемию туберкулёза в. Украине.

Ге нрих Ге рман Ро берт Кох (11. 12. 1843— 27. 05. 1910) — немецкий микробиолог. Открыл бациллу сибирской язвы, холерный вибрион и туберкулёзную палочку. За исследования тубер-кулёза награждён Нобелевской премией по физиологии и медицине в 1905 году.

История открытия и изучения свойств возбудителя • 1882 г. Р. Кох обнаружил и получил чистую культуру М. tuberculosis на кровяной сыворотке. • 1890 г. Р. Кох получил туберкулин. • 1911 г. Р. Кох за открытие возбудителя туберкулеза был удостоен Нобелевской премии.

История открытия диагностических проб • В 1907 г. австрийский педиатр Клеменс Пирке предложил накожную пробу с туберкулином для выявления людей, инфицированных микобактерией туберкулёза, и ввёл понятие аллергии. • В 1910 г. Шарль Манту внутрикожный метод введения туберкулина, который в диагностическом плане оказался чувствительнее накожного.

Франц Циль (1857— 1926) • — немецкий бактериолог, профессор в Любеке. Продолжая работы Пауля Эрлиха, Франц Циль создал в 1882 году карболфуксиновый краситель для окрашивания возбудителя туберкулёза. В 1883 году совместно с патологом Фридрихом Нельсеном разработал метод окраски, который используется для идентификации кислотоустойчивых микобактерий.

Получение вакцинного штамма (Франция) • В 1919 г. микробиолог Альбер Кальметт и ветеринарный врач Камиль Герен получили вакцинный штамм микобактерии туберкулёза для противотуберкулёзной вакцинации людей - «бациллы Кальметта — Герена (BCG — Bacilles Calmette — Guerin). • 1921 г. - впервые вакцина БЦЖ была введена новорождённому ребёнку.

Противотуберкулезные препараты • В 1943 г. • Зельман Ваксман и • Альбертом Шац - получение стрептомицина — первого противомикробного препарата, который оказывал бактериостатическое действие на микобактерии туберкулёза.

Классификация возбудителей • Mycobacterium tuberculosis (человеческий вид), • Mycobacterium bovis(бычий вид), Mycobacterium africanum, • Mycobacterium bovis BCG(БЦЖ-штамм бычьего вида), • Mycobacterium microti, • Mycobacterium canettii, • Mycobacterium pinnipedii, • Mycobacterium caprae.

Микобактерии в электронном микроскопе

М. tuberculosis, окраска по Циль-Нильсену: А- в чистой культуре Б – в микрокультуре В – в мокроте

Микобактерии туберкулёза (гр. +)

Внутриклеточное расположение микобактерий


Mycobacterium tuberculosis во флюорисцентном микроскопе

Рост микобактерий на среде Левенштейна

Колонии М. tuberculosis на среде Левенштайна. Йенсена в виде светло-кремового чешуйчатого налета с неровными краями, напоминающего цветную капусту. • Ниациновый тест на способность микобактерий синтезировать никотиновую кислоту (ниацин).
Колонии на плотной питательной среде

Незавершенный фагоцитоз микобактерий. Окраска по Цилю - Нильсену

Факторы, вызывающие повышенную восприимчивость человека к туберкулёзу: • Наиболее значимым в мире стал ВИЧ; • Курение (особенно более 20 сигарет в день) — увеличивает вероятность туберкулеза в 2 — 4 раза; • Диабет; • Тюремное заключение.

Основные клинические признаки: • Самыми первыми симптомами выступают неспецифические проявления интоксикации: слабость, бледность, повышенная утомляемость, вялость, апатия. • субфебрильная температура (около 37 °C, редко выше 38°), потливость, особенно беспокоящая больного по ночам, похудение. • Лимфаденопатия - генерализованное или локальное увеличение лимфатических узлов.

Милиарный туберкулез Казеозная пневмония с распадом

МИКРОБИОЛОГИЧЕСКАЯ ДИАГНОСТИКА Материал для исследования мокрота, промывные воды бронхов и промывные воды желудка, плевральная и цереброспинальная жидкости, моча, асцитическая жидкость и др. Ι. Бактериоскопическое исследование мазков из материала: • Прямая микроскопия - по Цилю-Нильсену. • Люминесцентная микроскопия. ΙΙ. Бактериологическое исследование • Посев на плотные элективные среды. ΙΙΙ. Ускоренные методы культивирования • Метод микрокультур (метод Прайса - Школьниковой) • Применение полностью автоматизированных коммерческих систем бульонного культивирования.

ΙV. Биологическая проба - морским свинкам подкожно или в/брюшинно вводят 1 мл исследуемого материала. Через 1 -2 мес развивается генерализованная инфекция с летальным исходом V. Туберкулинодиагностика – кожная аллергические проба Манту. VΙ. Экспресс-диагностика - РИФ, метод лазерной флуоресценции VΙΙ. ПЦР VΙΙΙ. ИФА - обнаружение антител к возбудителям туберкулеза в сыворотках крови.

Противотуберкулёзные лечебные препараты • Группа А: • - Изониазид • - рифампицин, • а также их производные.

Группа В: • Стрептомицин, канамицин, этионамид (протионамид), этамбутол, пиразинамид, флоримицин, циклосерин, производные фторхинолонов.

Группа С: • - ПАСК - натриевая соль, парааминосалициловой кислоты; • - БЕПАСК – кальциевая соль парабензиламиносалициловой кислоты; • - тиоацетозон (тибон).

Специфическая профилактика: • Живая вакцина BCG (Bacille Calmette. Guerin), полученная А. Кальметтом и С. Гереном. • Вакцинацию проводят на 5 -7 -й день в роддоме внутрикожно. • Ревакцинация – в 7 - 12 – 17 – 22 года и 27 -30 лет. • Ревакцинации подлежат только не инфицированные туберкулезом лица, у которых туберкулиновая проба отрицательная, поэтому перед ее проведением ставится проба Манту с 2 ТЕ.
68af7b9fc6f1a87ecc11035052a632a0.ppt